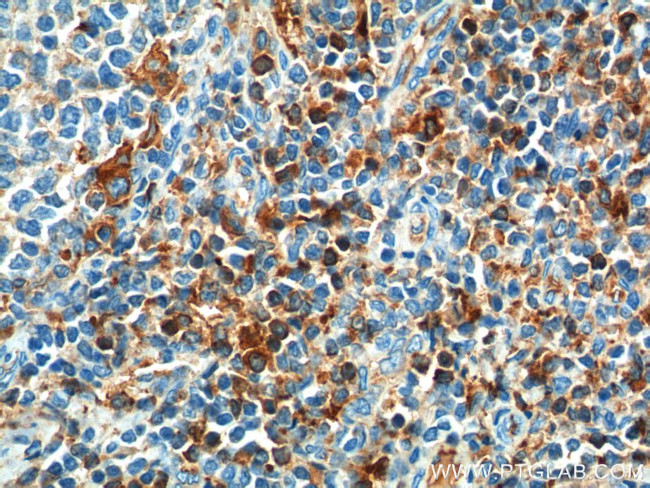
CD52 Antibody in Immunohistochemistry (Paraffin) (IHC (P))

Search
Proteintech
CD52 Polyclonal Antibody
{{$productOrderCtrl.translations['antibody.pdp.commerceCard.promotion.promotions']}}
{{$productOrderCtrl.translations['antibody.pdp.commerceCard.promotion.viewpromo']}}
{{$productOrderCtrl.translations['antibody.pdp.commerceCard.promotion.promocode']}}: {{promo.promoCode}} {{promo.promoTitle}} {{promo.promoDescription}}. {{$productOrderCtrl.translations['antibody.pdp.commerceCard.promotion.learnmore']}}
产品信息
21809-1-AP
种属反应
宿主/亚型
分类
类型
抗原
偶联物
形式
浓度
纯化类型
保存液
内含物
保存条件
运输条件
产品详细信息
Immunogen sequence: QTGLSGQND TSQTSSPSAS SSMSGGIFLF FVANAIIHLF CFS (20-61 aa encoded by BC000644)
靶标信息
CD52, also known as CAMPATH-1 antigen, is a glycoprotein that is expressed on the surface of various immune cells, including T and B lymphocytes, natural killer cells, and monocytes. It is involved in the regulation of immune responses and is being studied as a potential therapeutic target in various diseases, including multiple sclerosis, chronic lymphocytic leukemia, and autoimmune disorders. CD52 is the target of alemtuzumab, a monoclonal antibody that is used to treat these conditions by depleting immune cells that express CD52.
仅用于科研。不用于诊断过程。未经明确授权不得转售。
生物信息学
蛋白别名: Cambridge pathology 1 antigen; CAMPATH-1 antigen; CAMPATH-1 antigen precursor; CD52; CD52 antigen; CD52 antigen (CAMPATH-1 antigen); CDW52; CDW52 antigen (CAMPATH-1 antigen); Epididymal secretory protein E5; epididymis secretory sperm binding protein Li 171mP; He5; HEL-S-171mP; Human epididymis-specific protein 5
基因别名: CD52; CDW52; EDDM5; HE5
UniProt ID: (Human) P31358
Entrez Gene ID: (Human) 1043